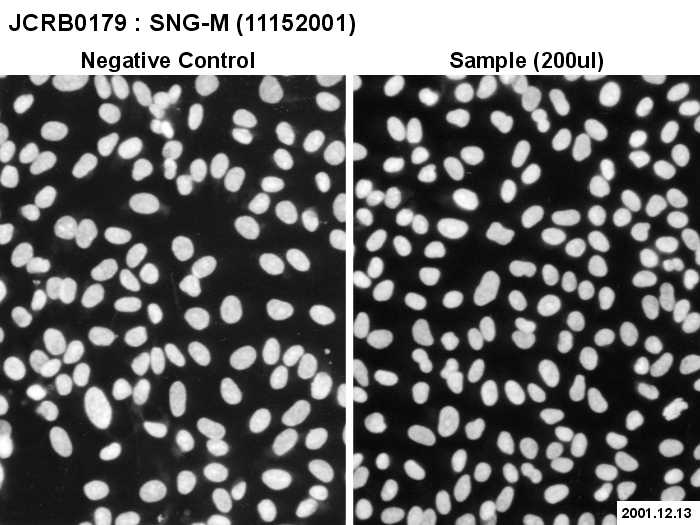

JCRB0179 SNG-M
細胞情報
細胞種類:一般細胞 (細胞分譲手数料はこちら)
| 細胞番号(JCRB) | JCRB0179 | 細胞名 | SNG-M |
|---|---|---|---|
| 生物種(日本語) | ヒト | 組織名(日本語) | 子宮 |
| コメント(日本語) | 子宮内膜がん | プロフィール | Intermedicately differentiated human adenocarcinoma cell line. |
| 別名 | 動物名 | human | |
| 系統名 | 学名・属名 | Homo | |
| 学名・種小名 | sapiens | 性別 | F |
| 年齢・月齢 | 52 | 細胞識別情報 | not done |
| (癌)原発組織名 | uterus | 病歴情報 | uterus tumor |
| 転移の有無(Y/N) | No | (癌)転移組織名 | |
| 遺伝的性質 | Mordal No. of chromosome is 40, Colony formation rate is 40%, Doubling time is 30 hours indicated by Nozawa,S. | 細胞寿命 | infinite |
| クライシスPDL | 形態 | epithelial-like | |
| 一般性状 | intermediately differentiated adenocarcinoma | 細胞分類 | tumor |
| 細胞樹立者名 | Ishiwata,I. and Nozawa,S. | 細胞寄託者 | Nozawa,S. |
| 分譲時制限 | コメント | The cells are responded to the progesterone. Mycoplasmas were decontaminated by MC210 in FDSC, 1990. | |
| 入手年 | 1990 | 培養培地 | Ham's F12 medium 80% with 20% fetal bovine serum. |
| 継代方法 | Cells harvested after treatment with 0.25% trypsin. | 継代時細胞数 | 2 x 10^5 cells/sq.cm. |
| 人種 | Japanese | 炭酸ガス濃度 | 5 % |
| 採取組織名 | metastatic lymph node | 組織型 |
| ウイルスDNA・RNA検出検査 (Detection of virus genome fragment by Real-time PCR) | |||||||||
|---|---|---|---|---|---|---|---|---|---|
| ウイルスDNA 検出検査 |
tested | ウイルスRNA 検出検査 |
tested | ||||||
| CMV | - | parvoB19 | - | HCV | - | HTLV-1 | - | ||
| EBV | - | HBV | - | HIV-1 | - | HTLV-2 | - | ||
| HHV6 | - | HTLV-1 | - | HIV-2 | - | HAV | - | ||
| HHV7 | - | HTLV-2 | - |
-/negative. +/positive. nt/not tested. (positive (+) does not immediately mean the production of infectious viral particles.) |
|||||
| BKV | - | HIV-1 | - | ||||||
| JCV | - | HIV-2 | - | ||||||
| ADV | - | HPV18 | - | ||||||
| Notes | |||||||||
| Reference | |
|---|---|
| Pubmed id:10545752 | Biological implications of growth factors on the mechanism of invasion in gynecological tumor cells. Ueda M,Ueki M,Terai Y,Ueki K,Kumagai K,Fujii H,Yoshizawa K,Nakajima M Gynecol Obstet Invest. 1999;48(3):221-8 |
| Pubmed id:8641991 | Effects of sex steroids and growth factors on migration and invasion of endometrial adenocarcinoma SNG-M cells in vitro. Ueda M,Fujii H,Yoshizawa K,Abe F,Ueki M Jpn J Cancer Res. 1996 May;87(5):524-33 |
| Pubmed id:7758945 | Trophinin and tastin, a novel cell adhesion molecule complex with potential involvement in embryo implantation. Fukuda MN,Sato T,Nakayama J,Klier G,Mikami M,Aoki D,Nozawa S Genes Dev. 1995 May 15;9(10):1199-210 |
| Pubmed id:2787771 | Adoptive cellular immunotherapy to the endometrial carcinoma cell line xenografts in nude mice. Shimizu H,Inoue M,Tanizawa O Gynecol Oncol. 1989 Aug;34(2):195-9 |
| Pubmed id:2746066 | [Glycosphingolipids in human uterine endometrium: expression of sulfoglycolipids and its fluctuation during menstrual cycle]. Kubushiro K Nihon Sanka Fujinka Gakkai Zasshi. 1989 Apr;41(4):397-404 |
| Pubmed id:3027213 | [Reorganization of human ovarian adenocarcinoma cells and endometrial adenocarcinoma cells cultured in double-layered floating collagen gels]. Tsumura N,Kudo R,Sawada N Nihon Sanka Fujinka Gakkai Zasshi. 1986 Dec;38(12):2157-70 |
| Pubmed id:3840512 | [Studies on the significance of PLD repair for radioresistance in human uterine adenocarcinoma cells]. Mitsunaga S Nihon Sanka Fujinka Gakkai Zasshi. 1985 Sep;37(9):1859-65 |
| Pubmed id:2580923 | [Experimental studies on combination chemotherapy based on cell cycle analysis]. Tsuboi T Nihon Sanka Fujinka Gakkai Zasshi. 1985 Apr;37(4):629-36 |
| Pubmed id:7276650 | [Studies on temperature sensitivity of human endometrial adenocarcinoma cells in vitro (author's transl)]. Udagawa Y Nihon Sanka Fujinka Gakkai Zasshi. 1981 Aug;33(8):1235-44 |
| Pubmed id:642036 | Effects of progesterone on human endometrial carcinoma cells in vivo and in vitro. Ishiwata I,Udagawa Y,Okumura H,Nozawa S J Natl Cancer Inst. 1978 May;60(5):947-54 |
| Pubmed id:858140 | Development and characterization of established cell lines from primary and metastatic regions of human endometrial adenocarcinoma. Ishiwata I,Nozawa S,Inoue T,Okumura H Cancer Res. 1977 Jun;37(6):1777-85 |
| Images |
|---|
![]() ![]() ![]() ![]() ![]() ![]() ![]() ![]() ![]() ![]() ![]() ![]() ![]() ![]() ![]() ![]() ![]() ![]() ![]() ![]() ![]() ![]() ![]() ![]() ![]() |
| Movies |
|---|
|
|
LOT Information
生細胞率、増殖速度、細胞濃度はバンクでのロット作製時の実測値として記していますが、保証値ではございません。また、倍加時間は継代間で計測したラフな値です。Viability/Growth rate/Cell number are represented as actual values measured at lot presentation in JCRB, but are not guaranteed values. Additionally, the doubling time is a rough value measured during passages.
| 細胞番号 | JCRB0179 | 細胞名 | SNG-M |
|---|---|---|---|
| 培養ロット番号 | 07212009 | 培養種別 | distribution |
| 培地 | Ham's F12 medium with 20% fetal bovine serum (GIBCO Cat. # 10099) | 培養温度 | 37 C |
| 継代時細胞数(濃度) | 7 - 20 x 10^4 cells/ml | 継代方法 | Cells were harvested after treatment with 0.25% trypsin and 0.02% EDTA. |
| 増殖速度 | approx 52 hrs | 凍結時生細胞濃度 | 4.2 x 10^6 |
| 凍結時生細胞率 | 67.7 | 使用抗生物質 | free |
| 継代数 | Unknown (16 at bank) | PDL数(プライマリ) | |
| マイコプラズマ検出 | - | 細菌汚染検出 | - |
| 真菌汚染検出 | - | アイソザイム検査・動物名 | Confirmed as human by NP, G6PD (type B), MD. |
| 染色体モード | 染色体情報 | ||
| 表面抗原 | DNA Profile (STR) | ||
| 接着性 | Yes | 導入外部遺伝子 | |
| 凍結培地 | 10% DMSO, 20% FBS - F12 | 炭酸ガス濃度 | 5% |
| 解凍後生細胞率 | 追加情報 |
| 細胞番号 | JCRB0179 | 細胞名 | SNG-M |
|---|---|---|---|
| 培養ロット番号 | 11152001 | 培養種別 | distribution |
| 培地 | Ham's F12 medium with 20% fetal bovine serum(Intergen RB52405). | 培養温度 | 37 C |
| 継代時細胞数(濃度) | 5.5 x 10^3 cells/sq.cm. | 継代方法 | Cells were harvested after treatment with 0.25% trypsin and 0.02% EDTA. Medium change once a week and subculture once a week. |
| 増殖速度 | NT | 凍結時生細胞濃度 | 2.8 x 10^6 |
| 凍結時生細胞率 | 94.6 | 使用抗生物質 | free |
| 継代数 | P16* | PDL数(プライマリ) | NT |
| マイコプラズマ検出 | - | 細菌汚染検出 | - |
| 真菌汚染検出 | - | アイソザイム検査・動物名 | NT |
| 染色体モード | NT | 染色体情報 | NT |
| 表面抗原 | NT | DNA Profile (STR) | |
| 接着性 | Yes | 導入外部遺伝子 | NT |
| 凍結培地 | Culture medium containing 5% DMSO. | 炭酸ガス濃度 | 5 % |
| 解凍後生細胞率 | 追加情報 |
| Images |
|---|
![]() ![]() ![]() ![]() ![]() ![]() ![]() ![]() ![]() ![]() ![]() ![]() ![]() |
| 細胞番号 | JCRB0179 | 細胞名 | SNG-M |
|---|---|---|---|
| 培養ロット番号 | 10062017 | 培養種別 | distribution |
| 培地 | Ham's F12 medium with 20% fetal bovine serum (FBS; Sigma Cat. # 172012). | 培養温度 | 37 C |
| 継代時細胞数(濃度) | 2.3 - 5.8 x 10^4 cells/mL | 継代方法 | Cells were harvested after treatment with 0.25% trypsin and 0.02% EDTA. |
| 増殖速度 | approx. 31 hrs. | 凍結時生細胞濃度 | 3.2 x 10^6 |
| 凍結時生細胞率 | 78.6 | 使用抗生物質 | free |
| 継代数 | Unknown (16 at bank) | PDL数(プライマリ) | |
| マイコプラズマ検出 | - | 細菌汚染検出 | - |
| 真菌汚染検出 | - | アイソザイム検査・動物名 | |
| 染色体モード | 染色体情報 | ||
| 表面抗原 | DNA Profile (STR) | ||
| 接着性 | Yes | 導入外部遺伝子 | |
| 凍結培地 | 10% DMSO, 20% FBS - Ham's F12 | 炭酸ガス濃度 | 5% |
| 解凍後生細胞率 | 78.6 | 追加情報 |
| 細胞番号 | JCRB0179 | 細胞名 | SNG-M |
|---|---|---|---|
| 培養ロット番号 | 11082022 | 培養種別 | distribution |
| 培地 | Ham's F-12 medium with 20% fetal bovine serum (FBS; GIBCO Cat. # 10437) | 培養温度 | 37 C |
| 継代時細胞数(濃度) | 2.3 - 6.0 x 10^4 cells/mL | 継代方法 | Cells were harvested after treatment with 0.25% trypsin and 0.02% EDTA. |
| 増殖速度 | approx. 23 hrs. | 凍結時生細胞濃度 | 1.0 x 10^6 |
| 凍結時生細胞率 | 98 | 使用抗生物質 | free |
| 継代数 | Unknown (17 at bank) | PDL数(プライマリ) | |
| マイコプラズマ検出 | - | 細菌汚染検出 | - |
| 真菌汚染検出 | - | アイソザイム検査・動物名 | |
| 染色体モード | 染色体情報 | ||
| 表面抗原 | DNA Profile (STR) | D5S818:9,13 D13S317:8,10,11 D7S820:10,11,12 D16S539:10,12 VWA:16,17,18,20 TH01:6,7 AM:X TPOX:8,9 CSF1PO:11,12 |
|
| 接着性 | Yes | 導入外部遺伝子 | |
| 凍結培地 | 10% DMSO, 20% FBS - Ham's F-12 | 炭酸ガス濃度 | 5% |
| 解凍後生細胞率 | 85 | 追加情報 |